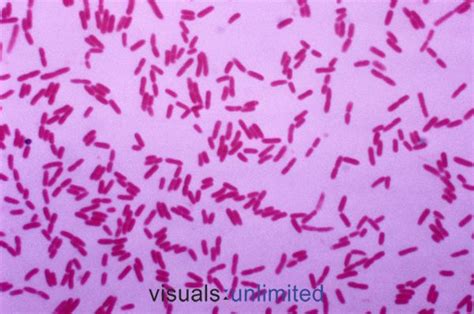

Pseudomonas Putida OSCLMS: A Bacterial Powerhouse
Pseudomonas putida OSCLMS: A Bacterial Powerhouse
Hey everyone! Today, we’re diving deep into the fascinating world of Pseudomonas putida OSCLMS, a microbial rockstar that’s making some serious waves in various scientific and industrial applications. You might be wondering, “What’s so special about this particular strain?” Well, buckle up, guys, because this bacterium is a versatile workhorse , packed with incredible capabilities that make it a valuable asset in fields ranging from environmental bioremediation to biotechnology. We’re talking about a microorganism that can break down stubborn pollutants, produce valuable chemicals, and even help in the development of new materials. It’s not just another bug in the petri dish; it’s a true champion with a whole lot to offer. Its genetic makeup and metabolic pathways are incredibly sophisticated, allowing it to adapt to and thrive in diverse environments, a trait that scientists are keen to harness for our benefit. The OSCLMS designation usually points to a specific strain that has been isolated and characterized for particular properties, often related to its ability to degrade certain compounds or its utility in specific biotechnological processes. Understanding these strains, like Pseudomonas putida OSCLMS, is crucial for unlocking their full potential and applying them effectively in real-world scenarios. We’ll explore its unique characteristics, the science behind its abilities, and the exciting future prospects that this amazing microorganism holds.
Table of Contents
Unpacking the Power of Pseudomonas putida OSCLMS
So, what exactly makes Pseudomonas putida OSCLMS stand out from the crowd? This particular strain is renowned for its extraordinary metabolic flexibility . Unlike many other bacteria, P. putida OSCLMS can utilize a remarkably wide range of carbon sources, including many complex and recalcitrant organic compounds that are often considered pollutants. This capability is a game-changer, especially in the realm of bioremediation . Imagine a world where we can use tiny biological agents to clean up oil spills, industrial waste, and agricultural runoff – that’s where strains like P. putida OSCLMS come into play. They essentially act as nature’s recyclers, breaking down harmful substances into less toxic or even harmless byproducts. The OSCLMS strain, in particular, has likely been selected or identified for its enhanced efficiency in degrading specific pollutants, making it a prime candidate for environmental clean-up operations. Its robustness means it can survive and function in challenging environments where other microbes might falter. This resilience, coupled with its powerful enzymatic machinery, allows it to tackle tough jobs that conventional methods struggle with. Furthermore, the genetic background of P. putida OSCLMS often harbors genes responsible for producing enzymes that are highly effective in breaking down aromatic hydrocarbons, pesticides, and other persistent organic pollutants. This is a major advantage for ecological restoration efforts. Scientists are actively studying its genome to understand the precise genetic mechanisms behind these degradation pathways, paving the way for genetic engineering to further enhance its capabilities or to transfer these useful traits to other microbial hosts. The potential applications are vast, from cleaning up contaminated soils and waterways to treating wastewater more effectively. It’s a sustainable and eco-friendly approach to tackling some of our most pressing environmental challenges.
The Science Behind Its Success: Metabolic Marvels
Let’s get a bit more technical, shall we? The metabolic prowess of Pseudomonas putida OSCLMS is rooted in its sophisticated genetic machinery and enzymatic systems. This bacterium possesses a diverse arsenal of enzymes, including dioxygenases and monooxygenases, which are crucial for initiating the breakdown of complex organic molecules, particularly aromatic compounds. These enzymes introduce oxygen atoms into the substrate, making it more susceptible to further degradation. P. putida OSCLMS has been studied extensively for its ability to degrade compounds like toluene, benzene, xylene, and even more complex polycyclic aromatic hydrocarbons (PAHs), which are common components of petroleum and industrial waste. The OSCLMS strain is often highlighted for its superior degradation rates or its ability to target specific, difficult-to-degrade molecules. Scientists have identified specific gene clusters, such as the tod (toluene dioxygenase) and xyl (xylene monooxygenase) operons, in various P. putida strains, and it’s highly probable that OSCLMS possesses enhanced versions or complementary pathways that contribute to its exceptional performance. Beyond pollutant degradation, P. putida OSCLMS is also a master of bioproduction . It can be engineered to produce valuable chemicals, biofuels, and bioplastics. For instance, its natural metabolic pathways can be modified to synthesize compounds like polyhydroxyalkanoates (PHAs), which are biodegradable plastics, or to overproduce useful enzymes for industrial processes. The ease with which its metabolism can be manipulated makes it an attractive chassis for synthetic biology applications. Researchers are constantly exploring ways to optimize its growth conditions and genetic pathways to maximize the yield of desired products. This includes techniques like metabolic engineering and systems biology approaches to gain a deeper understanding of its cellular processes. The adaptability of P. putida OSCLMS to various nutrient limitations and environmental stresses also makes it a robust candidate for industrial fermentation processes, where consistent and high-level production is key. Its ability to switch between different metabolic modes, utilizing various substrates, further solidifies its position as a key player in the future of green chemistry and sustainable manufacturing. The ongoing research into its genomics and proteomics is continuously revealing new insights into its incredible capabilities.
Environmental Applications: Cleaning Up Our Planet
One of the most significant areas where Pseudomonas putida OSCLMS shines is in environmental remediation . Guys, think about the massive problem of pollution we face globally – oil spills that devastate ecosystems, plastic waste accumulating in our oceans, and chemical contaminants leaching into our soil and water. P. putida OSCLMS offers a natural, sustainable solution . Its remarkable ability to break down a wide array of organic pollutants, including hydrocarbons, solvents, and pesticides, makes it an ideal candidate for bioremediation strategies. The OSCLMS strain, often specifically isolated or developed for its potent degradation capabilities, can be directly applied to contaminated sites, or its enzymes can be harnessed for targeted clean-up. For example, in the aftermath of an oil spill, introducing P. putida OSCLMS to the affected area can significantly accelerate the natural degradation process of crude oil components, preventing long-term environmental damage. Similarly, it can be used in wastewater treatment plants to break down complex organic molecules that are difficult to remove through conventional physical or chemical methods. This not only leads to cleaner water discharge but also reduces the energy footprint associated with treatment processes. The eco-friendly nature of bioremediation using bacteria like P. putida OSCLMS is a major advantage over traditional methods, which often involve harsh chemicals or energy-intensive physical processes that can create secondary pollution. Furthermore, research is exploring its potential in bio-augmentation , where the bacteria are introduced into an environment to supplement the existing microbial population and enhance its degradation capacity. This is particularly useful in environments where the native microbial community might be insufficient to handle the pollutant load. The robustness of P. putida OSCLMS allows it to survive and function effectively even in the presence of high contaminant concentrations, which can be toxic to other microorganisms. This resilience is a key factor in its success in real-world remediation projects. As we continue to grapple with the legacy of industrial pollution and the ongoing challenge of waste management, microorganisms like Pseudomonas putida OSCLMS will undoubtedly play an increasingly vital role in restoring and protecting our planet’s health. The biodegradation potential is truly a gift from nature, and P. putida OSCLMS is a prime example of how we can leverage it.
Biotechnological Innovations: From Waste to Value
Beyond cleaning up messes, Pseudomonas putida OSCLMS is also a powerhouse for biotechnological innovation , turning waste streams into valuable products. This is the essence of green biotechnology – using biological systems to create sustainable processes and materials. The OSCLMS strain, with its adaptable metabolism, serves as an excellent microbial platform for producing a variety of high-value compounds. One of the most exciting areas is the production of bioplastics , specifically polyhydroxyalkanoates (PHAs). PHAs are a family of biodegradable polymers that can replace conventional petroleum-based plastics, offering a sustainable alternative to combat plastic pollution. P. putida OSCLMS can be fed with simple sugars or even waste materials, and it naturally produces PHAs as an energy storage compound. By optimizing its growth conditions and potentially engineering its metabolic pathways, yields of PHAs can be significantly increased. This makes it possible to produce these eco-friendly plastics on an industrial scale. Another significant application is in the production of specialty chemicals and enzymes . Many industrial processes rely on enzymes for catalysis, and P. putida OSCLMS can be engineered to overproduce specific enzymes with desirable properties, such as thermostability or high catalytic activity. These enzymes can be used in various industries, including food processing, pharmaceuticals, and detergent manufacturing. Furthermore, its metabolic pathways can be manipulated to synthesize compounds like biofuels (e.g., isobutanol) or precursors for pharmaceuticals and fine chemicals. The ability of P. putida OSCLMS to utilize a broad range of carbon sources, including industrial byproducts and waste streams, makes these bioproduction processes highly cost-effective and environmentally friendly. Instead of disposing of waste, we can use it as a feedstock to create valuable products, contributing to a circular economy . The synthetic biology field is particularly interested in P. putida OSCLMS as a chassis organism because its genetic and metabolic pathways are well-understood and can be readily modified. This allows scientists to design and build new biological functions for specific industrial needs. The versatility of this bacterium means that the possibilities are nearly endless, from creating novel biomaterials to producing sustainable ingredients for consumer products. It’s a true testament to the power of microbial engineering in driving sustainable industrial development.
The Future with Pseudomonas putida OSCLMS
Looking ahead, the future for Pseudomonas putida OSCLMS looks incredibly bright, guys. As our global focus intensifies on sustainability, circular economies, and reducing our environmental footprint, the demand for bio-based solutions will only continue to grow. P. putida OSCLMS, with its inherent capabilities and its amenability to genetic and metabolic engineering, is perfectly positioned to meet many of these demands. We can expect to see it playing an even more prominent role in large-scale bioremediation projects , tackling complex pollution challenges in ways that are both effective and environmentally sound. Imagine vast tracts of contaminated land being restored, or waterways being purified, thanks to the tireless work of these microbes. In the realm of industrial biotechnology , P. putida OSCLMS will likely become a workhorse for producing a wider range of chemicals, materials, and fuels. This includes not just bioplastics and specialty chemicals but potentially even components for advanced materials and therapeutics. The development of precision fermentation techniques, combined with advanced genetic engineering tools like CRISPR-Cas9, will allow for even more fine-tuned control over its metabolic output, leading to higher yields and purer products. Furthermore, research into its interactions with other microorganisms and its role in complex microbial communities will open up new avenues for applications, perhaps in areas like agriculture or even human health (though the latter requires extensive safety research). The ongoing exploration of its genome and proteome will undoubtedly uncover even more hidden talents and capabilities within this remarkable bacterium. The continuous innovation in understanding and manipulating microbial systems means that we are only scratching the surface of what P. putida OSCLMS can achieve. It represents a sustainable, scalable, and biologically inspired approach to solving some of the most pressing challenges of our time, from environmental degradation to resource scarcity. So, next time you hear about Pseudomonas putida OSCLMS, remember that you’re hearing about a tiny organism with gigantic potential – a true hero in the ongoing quest for a greener, healthier planet. Its story is far from over; in fact, it’s just getting started!